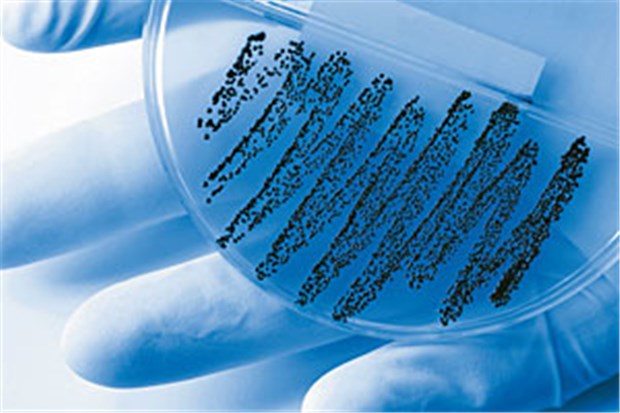

Länder wollen Kampf gegen Infektionen auch in Heimen
Den Ländern gehen die Pläne der Koalition zur verbesserten Klinikhygiene noch nicht weit genug: Pflegeheime und Arztpraxen sollen mit einbezogen werden.
Veröffentlicht:
Der Kampf gilt besonders den MRSA.
© picprofi / fotolia.com
BERLIN (sun/dpa). Den Bundesländern geht der Kampf der schwarz-gelben Koalition gegen Klinikkeime noch nicht weit genug. Ihrer Ansicht nach darf das geplante Infektionsschutzgesetz nicht auf Kliniken beschränken werden. Vielmehr müssen entsprechende Maßnahmen auch auf Pflegeheime und Arztpraxen ausgeweitet werden. Entsprechende Beschlüsse fasste der Bundesrat am Freitag in Berlin.
Die Länder fordern zudem, Pflegebedürftige und ihre Betreuer mit "klaren Hygienestandards" vor Infektionen zu schützen. Zudem sollen in Arzt- und Zahnarztpraxen, in den operative Eingriffe vorgenommen werden, sollen Verfahren zur Hygiene festgelegt werden. Schließlich seien operative Eingriffe grundsätzlich mit einem Infektionsrisiko behaftet, heißt es in der Begründung.
Das von der schwarz-gelben Koalition geplante Klinikhygienegesetz soll bereits Mitte Juli in Kraft treten. Damit will Bundesgesundheitsminister Philipp Rösler (FDP) einheitliche Standards für die Klinikhygiene schaffen. Unter anderem ist vorgesehen, dass auch niedergelassene Ärzte in den Kampf gegen die Klinikkeime einbezogen werden. Damit soll bereits weitestgehend ausgeschlossen werden, dass Keime in Kliniken eingeschleppt werden. Vertragsärzte sollen das Screening und die MRSA-Eradikation gesondert vergütet bekommen. In dem EBM wird dafür ab 2012 eine neue Gebührenposition aufgenommen.
Klinikinfektionen stehen in Deutschland immer noch auf der Tagesordnung: Jedes Jahr sterben zwischen 7500 und 15 000 Menschen an Infektionen, die im Zusammenhang mit einer medizinischen Behandlung stehen. Experten sind der Ansicht, dass sich 20 bis 30 Prozent der Infektionen durch die Einhaltung von Hygienemaßnahmen vermeiden ließen.








